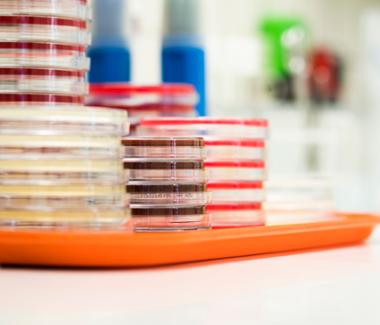
Deskundige infectiepreventie (36 uur)

Deskundige infectiepreventie (36 uur)

Dialyseverpleegkundige (24-36 uur)

Kok (32 uur)

Stafjurist (24-28 uur)

Technisch oogheelkundig assistent (28 uur)

Poli-assistent oogheelkunde (24 uur)

Orthoptist (16 uur)

Medewerker schoonmaak (20 uur)

Neonatologieverpleegkundige (28 uur)

Anesthesiemedewerker (32-36 uur)
